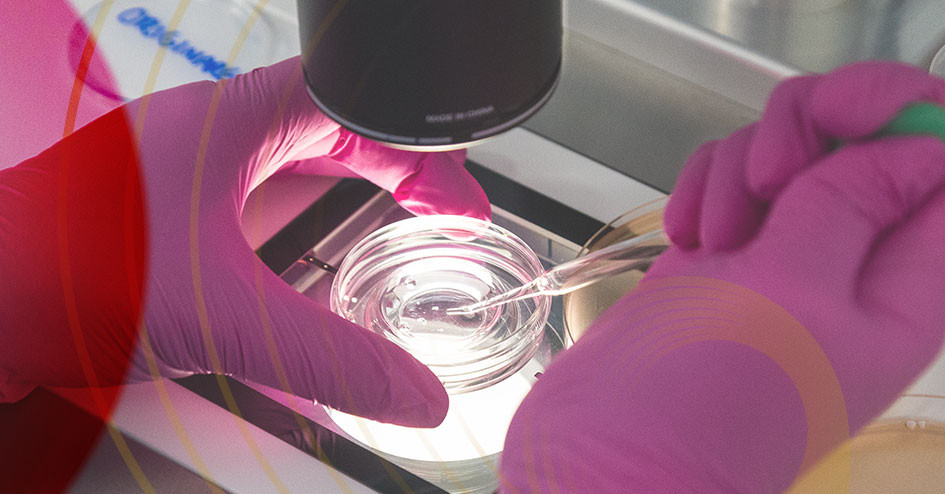

Saiba mais
Análise Genética
Mais segurança e consciência na formação da sua família Na Originare, acreditamos que a jornada reprodutiva deve ser vivida com acolhimento, informação e tecnologia de ponta. Por isso, oferecemos a Análise CGT (Carrier Genetic Test) como parte do nosso compromisso com um cuidado completo.
O que é
análise genética?
O CGT é um exame genético que identifica se os futuros pais são portadores de mutações que podem ser transmitidas aos filhos. Ser portador é algo comum — até 7 em cada 10 pessoas carregam alguma mutação genética recessiva — e não representa doença, mas pode impactar a saúde das futuras gerações. Realizar o CGT permite identificar riscos genéticos antes mesmo da formação dos embriões, tornando o planejamento reprodutivo mais seguro e consciente.

Para quem
é recomendado?
Ser portador é comum e não significa estar doente — mas pode impactar a saúde das futuras gerações.

Casais que desejam engravidar
naturalmente ou por fertilização in vitro;

Histórico familiar
de doenças genéticas recessivas;

Consanguinidade
Casais com grau de parentesco.
Passo a passo
Como funciona?
Saiba mais
Benefícios

Perguntas frequentes
FAQ
Preparamos respostas para as perguntas mais comuns sobre análise genética. Entenda cada etapa do tratamento, suas possibilidades e cuidados — com clareza, acolhimento e informação de qualidade.
Tire suas dúvidas
Entre em contato
Se você tem dúvidas, precisa de orientação ou quer agendar uma consulta, estamos aqui para ajudar. Entre em contato e conte com a nossa equipe para te acompanhar em cada passo da sua jornada.
Originare - Medicina Reprodutiva
Rua Joaquim Floriano, 413 - 8 andar , Itaim Bibi - São Paulo
CEP: 04534-011
Nossos